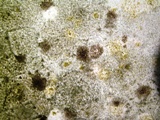
Грибки и плесень могут вызвать не только аллергические реакции организма. Как надолго удалить грибок и плесень?

Сколько стоит гидроизоляция подвала?
Сколько стоит гидроизоляция подвала?
Сколько стоит гидроизоляция подвала?
850 или 550: что больше?
Вы читаете этот текст потому что столкнулись с проблемой воды в подвале? Могут быть и другие причины. Но эта - самая первая. Одновременно с приходом весны или осени люди все чаще звонят к нам в Компанию с проблемами: «вода в подвале», « в подвале стена мокнет», «протекает крыша». Что делать? ГИДРОИЗОЛЯЦИЮ!
Что делать? ГИДРОИЗОЛЯЦИЮ!
Начнем с гидроизоляции стен подвала. В чем кроется основная причина протечек?
Основная причина протечек в подвале и намокании стен заключается в том, что сделанная ранее гидроизоляция подвала нарушена или просто прекратила выполнять свою функцию. Одно важное уточнение: традиционно гидроизоляцию подвалов в России выполняют с помощью битумных материалов. Так заложено в большинстве проектов. Но почему?!, - спросите Вы! Да потому что это уже стало традицией в России. Как говорится, «дешево и сердито». И лишь поэтому заводы по производству битумных материалов работают "на полную".
Как говорится, «дешево и сердито». И лишь поэтому заводы по производству битумных материалов работают "на полную".
Статистически подсчитано, что ремонт гидроизоляции подвала дома по стоимости оказывается в 3 раза! выше, чем устройство самой гидроизоляции. Подождите, и это еще не все… Иногда перед таким ремонтом появляется плесень, с портится мебель, тренажеры, сауна, оборудование, и пр. Можно продолжать и продолжать. Но у нас есть более удачная идея. Поговорим сейчас о гидроизоляции подвала дома.











